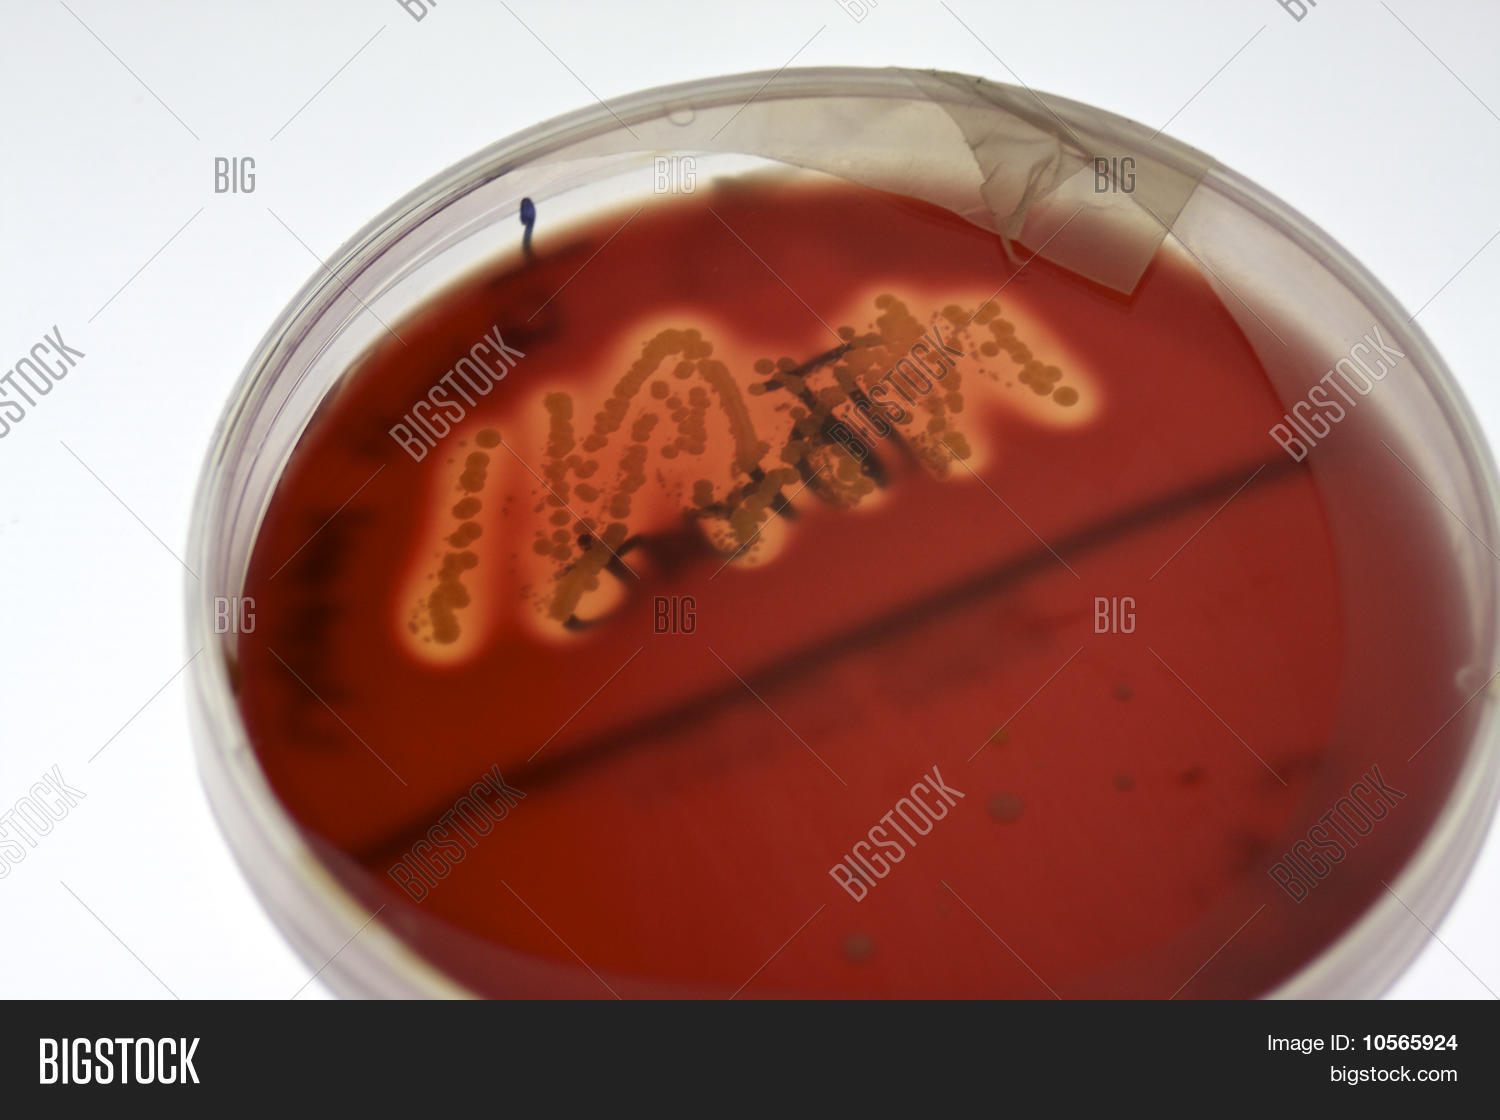

Зона гемолиза
Вокруг тебя весь мир слушать
Учитель рафаэля
Расщепление углеводов реакция
Вейгела санни фэнтези
Безнадежно устарело
Rbz sell
Карты хамстер комбат 5
Постоянный катетер в мочевом пузыре
Mein deine meine deine
Жесткие вилки 29
Сайт для девочек без регистрации
3 производителя процессоров
Мьюнинг стикер
Зона гемолиза 107 фотографий